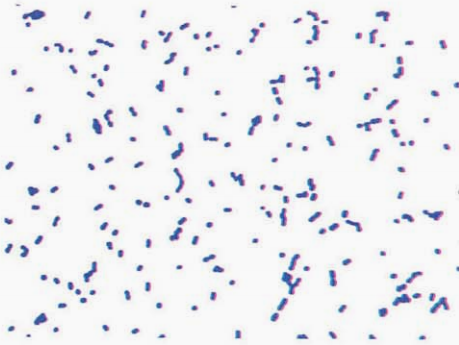
图 1 毗邻颗粒链菌纯培养镜下形态(革兰染色)
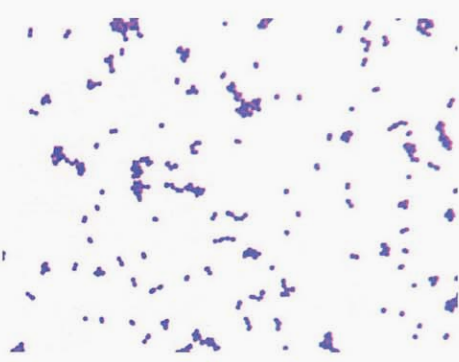
图 3缺陷乏养菌纯培养的镜下形态(革兰染色)
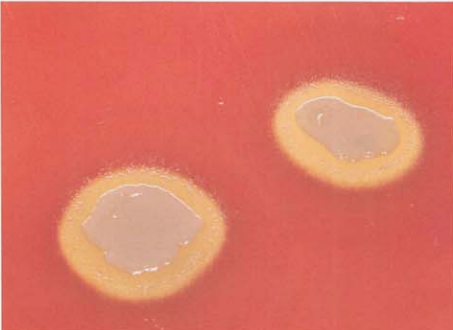
图 4 缺陷乏养菌在血琼脂平板上的

吡邻颗粒链球菌与缺陷乏养菌形态及生化特征
来源:武汉市灰藻生物科技有限公司 浏览量:354 发布时间:2026-01-12 20:21:02
一、颗粒链球菌
颗粒链球菌包括吡邻颗粒链球菌(G. adiacens)、苛养颗粒链球菌(G. elegans)等。
吡邻颗粒链菌 G. adiacens
(一)吡邻颗粒链球菌形态染色
革兰阳性球菌,呈卵圆形、球杆状和杆状,单个或短链排列,但也有部分革兰染色阴性(图 1)。
图 1 毗邻颗粒链菌纯培养镜下形态(革兰染色)
(二)吡邻颗粒链球菌培养特性
若疑似吡邻颗粒链菌的标本或培养物,将标本接种在血琼脂平板上,然后用金黄色葡萄球菌点种,置5% CO₂环境中35℃孵育18~24 h,在金黄色葡萄球菌周围形成极小、圆形、透明的菌落,即“卫星现象”(靠近金黄色葡萄球菌菌落周围生长,远离金黄色葡萄球菌不生长,见图 2)。或者将标本接种在含有半胱氨酸或盐酸吡哆醛培养基中。

图 2毗邻颗粒链菌在血琼脂平板上"卫星现象"(18~24h)
(三)吡邻颗粒链球菌生化反应
触酶试验、氧化酶试验阴性。主要生化反应见表 1。
表 1毗邻颗粒链菌主要生化反应
| 试验 | 结果 | 试验 | 结果 |
| 马尿酸钠水解 | — | 亮氨酸芳胺酶 | + |
| 精氨酸双水解酶 | — | 淀粉水解 | — |
| α-半乳糖苷酶 | — | 塔格糖 | + |
| β-半乳糖苷酶 | — | 海藻糖 | — |
| β-葡萄糖苷酶 | + | LAP | + |
| PYR | + | 七叶苷 | — |
注:+,90%以上菌株阳性;—,90%以上菌株阴性;PYR,吡咯烷酮芳基酰胺酶;LAP,亮氨酸氨基肽酶
(四)吡邻颗粒链球菌鉴别要点
- 本菌特征:革兰阳性球菌,在金黄色葡萄球菌菌落周围生长,呈“卫星现象”,触酶试验阴性。
- 与流感嗜血杆菌的鉴别:吡邻颗粒链菌是革兰阳性球菌,在葡萄球菌菌落周围呈“卫星现象”生长。而流感嗜血杆菌是革兰阴性杆菌,“卫星现象”依赖的是金黄色葡萄球菌生长所提供的V因子(NAD)和血平板提供的X因子(溶血素),而X因子、V因子对乏养菌和颗粒链菌的生长无影响。
(五)吡邻颗粒链球菌药敏试验的药物种类选择
颗粒链菌药敏试验的药物种类选择见表 2。
表 2药敏试验的药物种类选择
| 抗菌药物名称 |
| 必选: 青霉素、头孢噻肟、头孢曲松、万古霉素 |
| 可选: 氨苄西林、头孢呋辛、亚胺培南、美罗培南、红霉素、环丙沙星、左氧氟沙星、氯霉素、克林霉素 |
注:所有药敏试验只有MIC判读标准,具体参照CLSI M45-A3最新版本
(六)吡邻颗粒链球菌结果解释与要点提示
- 早在1961年此菌被认为是营养变异链菌(NVS)中的一员。直到1989年Bouvet等通过DNA-DNA杂交研究证明,这种细菌从分类学上与链球菌属其他细菌相差甚远,从而提出了缺陷链菌和吡邻链菌的分类概念。然而1995年日本科学家Kawamula等利用16S rRNA序列分析发现,这两种细菌属于乏养菌属,从而将这两类菌更名为缺陷乏养菌和吡邻乏养菌。在2000年时,Collins和Lawson利用16S rRNA的异质性和表型差异,对乏养菌进行了重新分类,乏养菌仅保留缺陷乏养菌一种,其余全部归为颗粒链菌属。
- 颗粒链菌属是人口咽部、生殖系统和肠道内的正常菌群,是一种条件致病菌,可引起感染性心内膜炎及其他疾病。若来自无菌部位如血液、深部组织、植入的假体装置、脓肿脓液,尤其是免疫缺陷患者,应进行药敏试验。乏养菌属和颗粒链菌属感染的发生率和死亡率均超过草绿色链球菌和肠球菌属。
- 若疑似吡邻颗粒链菌用金黄色葡萄球菌点种,在金黄色葡萄球菌周围形成极小、圆形、透明的菌落,即“卫星现象”。另一种方法是将标本接种在含有吡多醛的血琼脂平板(1000 ml培养基加入10 mg吡多醛和100 mg半胱氨酸)上可形成同样大小的菌落。
- 血培养瓶阳性报警后涂片见到革兰阳性球菌,但转种至血琼脂平板和巧克力平板未见细菌生长,应首先考虑颗粒链菌和乏养菌感染。
- 值得一提的是,某些菌株在未添加吡哆醛的普通血琼脂平板上仍然生长或不出现“卫星现象”,易被鉴定为其他链球菌。
- 颗粒链菌属对青霉素、头孢菌素、碳青霉烯类、氟喹诺酮类、大环内酯类均可出现耐药,尚未发现对万古霉素耐药的菌株。该菌引起的感染性心内膜炎通常推荐青霉素联合庆大霉素治疗4~6周。
- 颗粒链菌和缺陷乏养菌药敏方法参照CLSI M45-A3。需要添加盐酸吡哆醛的含5%羊血的平板,或者用含有0.001%盐酸吡哆醛的MH培养基,制备0.5麦氏单位菌悬液,置5% CO₂环境中35℃孵育18~24 h即可。
二、缺陷乏养菌 A. defectiva
(一)缺陷乏养菌形态染色
革兰阳性球菌,单个、成双或链状排列(图 3)。
图 3缺陷乏养菌纯培养的镜下形态(革兰染色)
(二)缺陷乏养菌培养特性
若怀疑感染缺陷乏养菌,将标本或培养物接种在血琼脂平板上,然后用金黄色葡萄球菌点种,置5% CO₂环境中35℃孵育18~24 h,在金黄色葡萄球菌周围形成极小、圆形、透明的菌落,即“卫星现象”(靠近金黄色葡萄球菌菌落周围生长,远离金黄色葡萄球菌不生长,见图 4)。或者将标本接种在含有半胱氨酸或盐酸吡哆醛培养基中。
图 4 缺陷乏养菌在血琼脂平板上的"卫星现象"(18~24h)
(三)缺陷乏养菌生化反应
触酶试验阴性。主要生化反应见表 3。
表 3 缺陷乏养菌的主要生化反应
| 试验 | 结果 | 试验 | 结果 |
| PYR | + | β-半乳糖苷酶 | + |
| LAP | + | 亮氨酸芳胺酶 | + |
| 万古霉素 | S | 支链淀粉 | + |
| 胆汁七叶苷 | — | 塔格糖 | V |
| 精氨酸双水解酶 | — | 海藻糖 | + |
| 马尿酸钠 | — | 乳糖 | + |
| α-半乳糖苷酶 | + | 6.5% NaCl | — |
注:+,90%以上菌株阳性;—,90%以上菌株阴性;S,敏感;V,不定;PYR,吡咯烷酮芳基酰胺酶;LAP,亮氨酸氨基肽酶
(四)缺陷乏养菌鉴别要点
- 本菌特征:革兰阳性球菌,触酶试验阴性,“卫星试验阳性”,PYR试验阳性,万古霉素敏感,营养要求高,在含有半胱氨酸或盐酸吡哆醛培养基中生长。
- 与吡邻颗粒链菌的鉴别见表 4。
表 4缺陷乏养菌和毗邻颗粒链菌鉴别的关键性试验
| 菌名 | α-半乳糖苷酶 | β-半乳糖苷酶 | 海藻糖 | 乳糖 |
| 缺陷乏养菌 | + | + | + | + |
| 吡邻颗粒链菌 | — | — | — | — |
注:+,90%以上菌株阳性;—,90%以上菌株阴性
(五)缺陷乏养菌药敏试验的药物种类选择
缺陷乏养菌药敏试验的药物种类参见颗粒链菌属章节。
(六)缺陷乏养菌结果解释与要点提示
在血培养中阳性报警涂片查见革兰阳性球菌,且转种于血琼脂平板和巧克力琼脂平板上等不生长时,应考虑乏养菌属及颗粒链菌属等可能,应做卫星试验或使用含0.001%盐酸吡哆醛的培养基培养。
该菌引起感染性疾病的报道不断增多,特别是免疫力低下的患者易发生菌血症、感染性心内膜炎、脑脓肿、外伤感染、骨髓炎、中耳炎、角膜炎及其他眼部感染等。
参考文献
周庭银, 章强强 主编. 临床微生物学诊断与图解(第4版)[M]. 上海: 上海科学技术出版社, 2019.
相关产品
HZB900261:相邻颗粒体 | Granulicatella adiacens
HZB571190:有缺陷的自养型 | Abiotrophia defectiva
敬请关注灰藻生物,共筑健康未来!
— 武汉市灰藻生物科技有限公司团队敬上
灰藻生物:我们期待着与客户共同成长,共创生命科学的美好未来!
更新日期:2026-01-05
编制人:木木
审稿人:小藻
